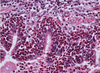
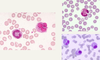
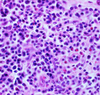

Intro, post-mortem morphologies, anomalies, etiologies, cell adaptations and injury, inflammation Flashcards
Types of pathology studies
structural, biochemical, functional in response to injurious agents and deprivations
General pathology
common reactions of cells and tissues to injurious stimuli
(e.g. acute inflammation in response to bacterial infections)
Systemic pathology
alterations and underlying mechanisms in organ specific diseases
(e.g. liver failure)
Disease
abnormal body process with or without characteristic signs; begins at the molecular and cellular level
Rudolph Virchow
father of modern pathology
Reversible cell injury
injury during the decline of cell function

Irreversible cell injury
injury during incline of biochemical alterations (cell death), ultrastructural changes, light microscopic changes, and gross morphologic changes

4 aspects of a disease process that form the core pathology
etiology, pathogenesis, molecular and morphologic changes, and clinical manifestations
Etiology (Etx)
the cause (causative agent, etiologic agent) or origin of a disease or disorder; the study or theory of the factors that cause disease and the method of their introduction to the host
(ex. Canine parvovirus type 2)
What are the 2 major classes of etiology?
genetic/intrinsic (e.g. inherited mutations, disease-associated gene variants, polymorphism) and acquired (extrinsic, infectious, nutritional, chemical, physical)
Tissue from a raven; what is the etiology?

Poxvirus
Pathogenesis
the mechanisms of disease development; sequence of events from INITIAL stimulus to the ULTIMATE expression of the disease in the response of cells or tissues to the etiology; always end it with the morphological diagnosis
(ex. oropharyngeal infection > viremia > infection and death of rapidly dividing cells from crypts > necrohemorrhagic enteritis)
Pathogenesis (img)

Grain overload, rumenal acidosis, mucosal damage, opportunistic fungal infection, vasculitis, ischemia and mucosal ulceration
Molecular and morphological changes
refers to biochemical and structural alterations induced in the cells and organs of the body; the changes may be characteristic (pathognomic) of a disease or diagnostic of an etiologic process
Clinical manifestations
results of genetic, biochemical and structural changes in cells and tissues; manifests as functional abnormalities such as signs (animals) and symptoms (humans, what the patient feels and tells you); injury to the cells and to the extracellular matrix finally leads to tissue and organ injury
What are the molecular and morphologic changes of the image? ( MDx)
Clinical history and signs: 3 week old puppy, anorexia, dypsnea, abd pain upon palpation, normal rectal temperature

Multifocal, acute renal necrosis and hemorrhage or necrohemorrhagic nephritis
What is the etiology?
Clinical history and signs: 3 week old puppy, anorexia, dypsnea, abd pain upon palpation, normal rectal temperature

Canine herpesvirus-1 (CHV-1)
- red spots are from the virus targeting endothelium
What is the pathogenesis?
Clinical history and signs: 3 week old puppy, anorexia, dypsnea, abd pain upon palpation, normal rectal temperature

Transmission CHV-1 to pup at birth >incubation period of up to 1 week > virus replicates at temperature lower than 37C (98.6F) > endothelial cell tropism > multifocal necrosis in numerous organs
Diagnosis
concise statement or conclusion concerning the nature, cause, or name of a disease
Types of diagnosis
clinical diagnoses, differential diagnoses (DDx), morphologic diagnoses (MDx), etiologic diagnoses (Edx, agent and organ), clinical pathologic diagnosis
Clinical diagnosis
based on case history (Hx), clinical signs, physical examination; may provide differential diagnosis
Differential diagnosis (DDx)
list of diseases that could account for the evidence or lesions of the case; DAMNITV scheme; clinical or morphological
(ex. clinical: anticoagulant rodenticides, canine distemper, hemorrhagic gastroenteritis due to Clostridium spp.)
Morphologic diagnosis (MDx)
based on the predominant lesion(s) in the tissue(s); macroscopic, microscopic; summary of the lesion, but generally does not describe what is causing the lesion
- location (organ tissue)
- distribution (focal, multifocal, locally extensive, diffuse)
- severity (mild, moderate, severe)
- duration/time (acute, chronic)
- nature (degenerative, inflammatory, neoplastic) of the lesion; if inflammatory remember to classify the type of exudate
(ex. [small intestine], segmental necrohemorrhagic enteritis)
Main types of pathological processes
degeneration/necrosis, inflammation & repair, tissue deposits/pigmentations, circulatory disorders, disorders of growth (adaptation vs. neoplasia vs. malformations)
Etiologic diagnosis (EDx)
a more definitive dx and names the specific cause(s) of the disease; restricted to 2 words only (causative agent and site of lesion)
(ex. parvoviral enteritis)
What is the MDx?

Pulmonary artery, diffuse chronic arteritis with intralesional nematodes (Dirofilaria immitis)
What is the EDx?

Verminous/parasitic arteritis or Dirofilarial arteritis
What is the EDx?

Bacterial dermatitis or Streptococcal dermatitis
Clinical pathologic diagnosis
based on the changes observed in the chemistry of fluids and the hematology
Prognosis
it combines pro (before) and gnosis (knowing); refers to the course of a disease or the outcome; diagnosis enables the clinician to predict the prognosis; “good”, “intermediate”, or “poor”
Pathognomonic
(test question)
characteristic or indicative of a specific disease
(ex. canine herpesvirus-1 nephritis)
Description of gross lesions is based on:
- localization (where is the change?)
- distribution (focal, multifocal, diffuse)
- size (measure, weight or estimate what % of the organ is affected)
- shape (ovoid, flat, nodule, well delimited, encapsulated)
- color
- consistency (soft, firm, hard; lung with pneumonia is dense compared to normal elastic)
- texture (fluid, pasty, fluctuant, smooth/rough)
- outline (surfaces: excavated- something missing, prominent- something added)
- number/extent
- content
- odor
What is the MDx and EDx of this cat?

(test question)
MDx: multifocal to coalescing, granulomatous nephritis
EDx: mutated feline coronavirus
Autolysis
(test question)
self-digestion or degradation of cells and tissues by the hydrolytic enzymes normally present in tissues (postmortem change); occurs after somatic death; those tissues with greater concentration of proteolytic enzymes will undergo autolysis first (GI tract, pancreas, gall bladder, liver, kidney)
Somatic death
due to total diffuse hypoxia; cells degenerate as described for hypoxic cell injury
Putrefaction/decomposition
process by which post mortem bacteria break down tissues; gives color, texture changes, gas production, odors
Death of the whole body
death due to discontinued cardiac activity and respiration
Morphologic appearance of postmortem changes vary depending on:
cause of death, environmental and body temperature, microbial flora
Cool environmental temperature and refrigeration delays autolysis, delaying putrefaction, except:
ruminants forestomach, equine cecum and ascending colon
T or F: ingesta will continue to undergo bacterial fermentation (producing gas and heat) even after death?
True
Early postmortem changes
- Livor mortis (lividity, hypostasis): if an animal dies on the left side, more blood will travel to that side
- Rigor mortis (rigidity): depends on the size of the animal, starts from the head down to the tail, depends on the outside temperature (slower if colder)
-
Algor mortis (cooling): depends on the outside AND body temperature
- Corneal clouding
- Tache noire: black discoloration of the whites of eyes
- Drying and dark discoloration of lips, tongue, scrotum
Rigor mortis
refers to the contraction of the muscles after death; begins at 1-6 hours post death, persistent 1-2 days; high heat and high activity before death accelerate the onset of rigor mortis
NO RIGOR MORTIS IN CARCASS WITH ANTRHAX because edema factors inhibits muscle contraction stimulating cAMP
Algor mortis
cooling of the body post mortem, depends on the temperature of the body (and environment) at the time of death
How do you obtain the temperature from a carcass?
hole in the skull, site where the temperature in brain decreased in a relatively straight line to ambient temperature about 18 hours after death; other sites many variants (wool, fat); changes of temperature curve
Livor mortis
(test question)
aka hypostatic congestion; occurs about 1 hour post-mortem; gravity will pull blood post death; variation in color of tissues like skin, lung, heart, kidneys, liver; in some areas the tissues will be more red and in other areas pale due to that the blood was kept away
Describe post-mortem clotting
(test question)
shiny in appearance, never attached to vessel wall; occurs several hours post death in the heart and vessels; influenced by ante mortem changes in blood (ex. Warfarin poison, hereditary coagulapathies can delay or cause failure of blood to clot)
Chicken clot appearance (postmortem clotting)
due to separation of RBCs to the bottom and clotted serum at top (red and yellow); differentiate this from pre-mortem clotting!!
What type of clots are pictured (pre-mortem, post-mortem, or chicken clot)?

Top: normal post-mortem clots
Bottom: “Chicken” clots
What type of clot is this (pre-mortem or post-mortem)?

Pre-mortem clot (mural thrombi and thromboemboli): attached to vessel walls (arterial type), loosely attached to vessel walls (venous thrombi, may resemble post mortem clots), dry and duller, laminated, friable
What type of clot is this (pre-mortem or post-mortem)?

Post mortem clots: unattached to vessel walls, shiny and wet, perfect cast of vessel lamina, elastic
What is hemoglobin imbibition?

post-mortem red staining of tissue, especially the heart, arteries and veins; Hg is released by lysed RBCs and penetrates the vessel wall and extends into the adjacent tissues; however, Hg staining can occur in acute intravascular hemolysis (pre-mortem)
Bile imbibition

when bile in the gallbladder starts to penetrate the wall and stains the adjacent tissues yellowish to greenish brown post-mortem; tissues stained are those in contact with the gall bladder (liver, intestines, diaphragm); takes a while to occur
Is bloating a pre-mortem or post-mortem morphological change?
(test question)
results from post-mortem bacterial gas formation in the lumen of the GI tract; herbivores bloat faster; differentiate from ruminant tympany (pre-mortem)
Comparison: pre-mortem bloat will cause a line of color change in the distal third of the esophagus
What causes corneal opacity/clouding (morphologic appearance of postmortem change)?

due to dehydration of cornea/due to cold temperatures of the carcass; most different from cataracts; differentiate from Blue Eye disease (canine Coronavirus)
What is pseudomelanosis?

refers to greenish-black discoloration of tissues post-mortem; decomposition of blood by bacterial action forming hydrogen sulfide with iron; occurs soon after death (like in the gut), also will be common to see in those tissues in contact with the gut (kidney, liver, spleen, even the gut wall itself)
Marcus Terentius Varro (1st century BC, ancient Rome)
warned his contemporaries to avoid swamps and marshland because of the risk of diseases
Miasma theory (medieval times Europe, India, China)
diseases such as Cholera, Chlamydia, or the Black Death were caused by a miasma, a noxious form of “bad air” also known as “night air”
Robert Koch
formed Koch’s postulates; identified the specific causative agents of tuberculosis, cholera, and anthrax; gave experimental support for the concept of infectious disease
Example of infectious diseases > one etiological agent > one disease
Cryptococcosis

(img: thalamus, cerebellum and mesecephalon; “cavitational” lesions caused by Cryptococcus neoformans; multifocal distribution in both gray and white matter)
Example of single gene disorder > one inherited disease
Spider lamb chonrodysplasia

(img: multiple, disorganized ossification centers resulting in variation of the size, shape and orientation of the vertebrate)
Example of one etiological agent > multiple diseases
(test question)
Hepatosis dietetica (nutritional hepatic necrosis) from vitamin E (antioxidant) and/or Selenium deficiency
(img: diffuse, hemorrhagic)
Also, encephalomalacia in chicken, Rickets in puppies, malaisia in adult dogs from vitamin E deficiency (also A and D)

Example of multifactorial > multiple factors, etiologies, external triggers (risk factors, promoters) > one disease
(test question)
most common method; gastric ulcer, pulmonary edema, autoimmune diseases, Bovine Respiratory Disease (BRD) complex, pneumonias of pigs, bovine enzootic pneumonia

What are some causes of gastric ulcer (pars esophagea) in pigs?
(multiple factors > one disease)
(test question)
in growing pigs; stratified squamous epithelium surrounding the cardia (pars esophagea); causes include ingestion of finely ground grain or pelleted feed, possibly vitamin E deficiency, fermentation of sugars in the feed, stress of confinement rearing

Animals dying of sepsis, toxemia, aspiration of gastric contents, pancreatitis > fulminating pulmonary edema because of: (what is the pathogenesis?)
(multiple factors > one disease)
hyperreactive macrophages -> directly or indirectly generate too many cytokines -> some cytokines prime neutrophils stationed in the lung capillaries -> release of enzymes and free radicals -> diffuse endothelial and alveolar damage -> pulmonary edema; analogous to ARDS/shock lung (acute/adult respiratory distress syndrome) in humans
What is a factor that causes Systemic Lupus Erythematosus (autoimmune diseases)?
(multiple factors > one disease)
Type III hypersensitivity

What are some factors that cause pneumonia of pigs?
(multiple factors > one disease)
Host (age, genetic makeup, immune status), infectious agents (virus, bacteria, mycoplasma), environmental determinants (humidity, temperature, ammonia concentrations, ventilation), management practices (crowding, mixing of animals, air quality, nutrition, stress)
What are the main types of etiologies?
genetic, microbial, immune mediated, toxic, trauma, idiopathic, nutritional, metabolic
What are the building blocks for general pathology?
adaptation, degeneration and cell death, tissue deposits and pigmentation, inflammation and repair, circulatory disorders, genetic disorders, diseases of immunity, neoplasia, microbial infections
What type of pathological process is this?

adaptation, degeneration and cell death: squamous metaplasia of the esophagus (parrot)
- (Description: avitaminosis A, no lubrication, glandular cells replaced by keratin)*
- Another example: prostatic hyperplasia, benign but the large size can cause a lot of damage (dog)*
What type of pathological process is this?

inflammation and repair: embolic nephritis (horse kidney)
(Description: Actinobacillus equuli; growth in the cortex [glomerulus] usually occurs first, red around the pus, bacteria lodged in the glomerulus)
What type of pathological process is this?

(top normal, bottom abnormal) tissue deposits and pigmentations
(Description: defect in heme synthesis caused by a deficiency in uroporphyrinogen III cosynthetase; decoloration of bones, can see discoloration in teeth as well, accumulation of bilirubin, can see in UV light)
What type of pathological process is this?

circulatory disorder: chronic passive congestion (“nutmeg liver”) of a cow, right sided heart failure,
(Description: ingestion of hepatotoxin (Wedelia glauca); venous blood not reaching the heart, hepatocytes do not get oxygen which causes tissue death, replaced by connective tissue and lipid inclusions)
What type of pathological process is this?

(test question)
genetic disorder: globoid cell leukodystrophy (a type of lysosomal storage disease, dog)
- (Description: defect in an enzyme (galactosylceraminidase); special stain used for myelin (blue), periphery not stained because not enough myelin, impairment of function of lysosomes)*
- Another example: male pseudohermaphrodite, external female genitalia and testicles*
What type of pathological process is this?

disease of immunity: bovine nasal epithelium, acute allergic rhinitis with secondary plant foreign body
(Description: type I hypersensitivity reaction (plant allergen); mast cells and eosinophils accumulate)
What type of pathological process is this?

neoplasia: bovine abomasal lymphoma, bovine leukemia virus
What type of pathological process is this?

microbial infection: epithelial plaques, papular stomatitis (inflammation of mouth and lips), hard palate mucosa (calf),
(Description: parapoxvirus [causes Orf in sheep and goats]; plaques are yellow and multifocal)
DAMN IT V
acronym for a clinical investigation plan, based on probable pathophysiologic causes of the disease present
- degenerative, developmental (degenerative is a mechanism)
- allergic, autoimmune
- metabolic, mechanical
- nutritional, neoplastic
- inflammatory, infectious, iatrogenic, immune-mediated, ischemic, idiopathic
- toxic, traumatic, vascular (vascular is a mechanism)
Idiopathic
unknown cause or spontaneous origin
(ex. epilepsy, canine polyarteritis, pulmonary fibrosis, laryngeal hemiplegia, renal amyloidosis, hypertrophic cardiomyopathy)
Cell adaptation
occurs when the cell homeostasis is distorted by stresses or pathologic stimuli; in this stage, cells preserve viability and function; it is a reversible change; principal responses of adaptation are atrophy, hypertorphy, hyperplasia, metaplasia, dysplasia

Homeostasis
tendency to stability in the normal body states of the organism; it is the ability to maintain internal equilibrium by adjusting its physiological processes
Atrophy
(test question)
decrease in size and/or number of the cells and their metabolic activity after normal growth has been reached (cells are not dead); decrease in protein synthesis and increase in protein degradation in cells;
causes: decreased workload (immobilized animal), denervation, decreased blood supply or oxygen, inadequate nutrition (generalized atrophy because body is trying to adapt), loss of endocrine stimulation, aging; a type of adaptive cell change
Examples of atrophy
muscle disuse in a limb that is in a cast, sedentary atrophy, atrophy of adrenal cortex by reduction of ACTH stimulation (steroid therapy), atrophy in tissues adjacent to a tumor due to pressure and compromised blood supply, physiologic atrophy (non-lactating mammary gland)
- ex. serous atrophy of fat (loss of nutrients, vitamin E deficiency), no fat on the heart, white lines seen on the surface (dilated lymphatic vessels), yellow, gel-like bone marrow*
- ex. hydrocephalus with compression atrophy (cat), fluid accumulation in the brain, defect with draining*

Hypertrophy
increased size of cells and their functions (synthesis of more organelles and structural proteins, bigger cells), more common in cells with little replication (stable or permanent cells: cardiomyocytes, neurons); a type of adaptive cell change
Examples of hypertrophy
(test question)
hypertrophic pregnant uterus, weightlifter (physiologic hypertrophy), x-linked muscular hypertrophy (genetic disease in cats), cardiac hypertrophy from hypertension or aortic valve disease (pathologic hypertrophy, common in animals with longer life spans, transcription factors produced from increased work load such as mechanical stretch, agonists, growth factors)

Concentric vs. eccentric hypertrophy
eccentric hypertrophy is thinner because it is compensating (left concentric, right eccentric)

Hypertrophic cardiomyopathy (HCM) is common in what breed of cats?
common in Maine coon cats (more prone to have this dz earlier than other species), mutation in MYBPC3 gene (inherited autosomal dominant)

Hyperplasia
increase in the number of cells of an organ, cells capable of replication, may occur concomitantly with hypertrophy; a type of adaptive cell change
Examples of hyperplasia
- hormonal (breasts during pregnancy)
- compensatory (hepatectomy, also in kidneys)
- pathologic most commonly caused by excessive hormonal or growth factor stimulation (epidermal thickening from repeated irritation, respiratory mucosa in viral infections),
- fibrous hyperplasia (formerly part of fibrous or fibromatous epulis, gingival hypertrophy, canine)
SCC epidermal hyperplasia proceeds to dysplasia, carcinoma in situ and invasive squamous cell carcinoma (carcinoma in situ, when cells have already gone neoplastic transformation but not invading basal membrane yet)
(ex. cat’s ears from sun exposure, horses eyelids/oral cavity)

Dysplasia
refers to abnormal development (mostly of epithelial cells); term mostly used in neoplastic processes, near synonym is carcinoma in situ; cells lose polarity
Metaplasia
change in phenotype of a differentiated cell, response to chronic irritation (cell withstand stress), may result in decreased functions or increased propensity for malignant transformation (neoplasia), reversible if cause is removed, most often in epithelial cells (urinary bladder, distal esophagus canine)

Examples of metaplasia
chronic irritation in lungs, vit-A deficiency, estrogen toxicity (mainly in urinary bladder/genital tract), mammary tumors
What is the MDx (atrophy, hyperplasia, hypertrophy, metaplasia, or dysplasia)?

feline kidney, nephrolith (xanthinuria) with hydronephrosis, cortical and medullary atrophy and medullary fibrosis, diffuse

Is this atrophy, hyperplasia, hypertrophy, metaplasia, or dysplasia?

cat: squamous cell carcinoma, dysplasia
What is the MDx and etiology (atrophy, hyperplasia, hypertrophy, metaplasia, or dysplasia)?

snake stomach, diffuse marked chronic gastric hypertrophy from Cryptosporidium serpentis
What is the MDx (atrophy, hyperplasia, hypertrophy, metaplasia, or dysplasia)?

feline stomach gastric lymphoid hyperplasia, multifocal (white nodules)
What is the MDx (atrophy, hyperplasia, hypertrophy, metaplasia, or dysplasia)?

canine liver, hepatocellular carcinoma with nodular hyperplasia
What are the 2 MDx (atrophy, hyperplasia, hypertrophy, metaplasia, or dysplasia)?

canine kidney, MDx1: hydronephrosis with secondary severe diffuse cortical atrophy
MDx2: ureter, hydroureter
Normal cell components
cell membranes, cytosol, mitochondria, nucleus, nucleolus, ER, Golgi complex, lysosomes, cytoskeleton, extracellular matrix

How is DNA of a normal cell organized?
antiparallel, 5’ to 3’ and 3’ to 5’; purine (adenine, guanine) is bound to a pyrimidine (cytosine, thymine) by hydrogen bonds (A:T and G:C); the helix occurs naturally because of the bonds in the phosphate backbone; organized by histones into nucleosome bead that are coiled and packed into chromosomes
How is chromatin of a normal cell organized?
DNA is organized around histones into nucleosomes; nucleosomes are wound into a helix to form chromatin; chromatin wound again into supercoiled chromosomes

What is the function of the nucleus?
(test question)
storage of genetic material/location of the genome; DNA complex to protein = chromatin: euchromatin (uncoiled, transcriptionally active) and heterochromatin (coiled, transcriptionally inactive)
What is a nucleolus?
(test question)
organelle of the nucleus, composed of RNA, protein, chromatin, functions in the synthesis of rRNA, prominence is a subjective measure of a cell’s synthetic activity

Normal cellular functions are compartmentalized within membrane-bound organelles which allow for:
isolation of potentially harmful substances (e.g. degradative enzymes, reactive metabolites) and the creation of unique intracellular environments (e.g. low pH, high Ca++ concentrations)
What is the function of the rough endoplasmic reticulum?
site of protein synthesis (esp. EC); contains ribosomes
What is the function of the smooth endoplasmic reticulum?
locus of enzymes that metabolize steroids, drugs, lipids and glycogen; lacks ribosomes
What is the function of the Golgi apparatus?
synthesis of complex proteins and the production of secretory vesicles and lysosomes
What is the function of endosomal vesicles?
shuttles internalized material within cell and directs newly synthesized material to cell surface or cell organelle
What is the function of lysosomes?
digests macromolecules (waste management)
What is the function of proteasomes?
selectively degrades denatured proteins and release peptides (waste management)
What is the function of peroxisomes?
breakdown fatty acids and generates hydrogen peroxide (waste management)
Autophagy vs. heterophagy
autophagy is to “eat oneself” while heterophagy is the digestion within a cell of a substance taken in by phagocytosis
Cell polarity
refers to the spatial differences in shape, structure, and function of cells
(ex.: epithelial cells: apical surface and basilar surface are exposed to different environments and have different functions)
What are the functions of the cytoskeleton?
(test question)
contents and position of cell organelles are regulated by the cytoskeleton; responsible for cell movement, maintains cell shape and intracellular organization, can move organelles and proteins within the cell
What are the components of the cytoskeleton?
- actin microfilaments (cell structure and movement)
- intermediate filaments (support)
- microtubules (protein movement and signaling)

What are the 2 main functions of cell membranes?
selective barrier and structural base for enzymes and receptors

What are the functions of membrane proteins?
transport channel, enzyme, cell surface receptor, cell surface markers, cell adhesion, attachment of cytoskeleton

Mitochondria characteristics:
evolved from ancestral prokaryotes engulfed by eukaryotes, contain their own DNA, maternal inheritance
What are the functions of mitochondria?
(test question)
site of aerobic metabolism and regulator of apoptosis (leakage of cytochrome C > activation of caspases)

Which part of the nucleus is not being actively transcribed (heterochromatin, euchromatin, histones, or nucleolus)?

(test question)
heterochromatin
What is cell injury?
damage or pathologic alterations in molecules and/or structure that can occur in cells and extracellular components
What are some extrinsic causes of cell injury (etiology)?
physical trauma, viruses, toxins
What are intrinsic causes of cell injury (etiology)?
genetic mutations (enough to become neoplastic, apoptosis)
What are both extrinsic and intrinsic causes of cell injury?
workload imbalance, nutrional abnormalities, immune dysfunction
When does cell injury occur?
when the cell cannot maintain a steady state
What are some causes of cell injury?
oxygen deficiency, physical agents, infectious agents, nutritional deficiencies and imbalances, genetic derangement, workload imbalance, chemicals, drugs, toxins, immunologic dysfunction, aging
What is oxidative phosphorylation?
when O2 is required for cellular respiration
What is hypoxia?
(test question)
partial reduction in O2 delivery to a tissue, inadequate oxygenation of blood, reduced transport of O2 in blood, reduction in blood supply (ischemia), blockage of cell respiratory enzymes (e.g. cyanide)
What is anoxia?
no oxygen delivery to a tissue, necrosis
What are physical agents that cause cell injury?
trauma, temperature extremes, electrical injury, ionizing radiation (UV light, microwaves)
What are infectious agents that cause cell injury?
- viruses
- obligate intracellular parasites; use host cell enzyme systems
- cell survival depends on method viruses leave the cell
- bacteria
- toxins, overwhelming and uncontrolled replication
- fungal (mycosis)
- progressive, chronic inflammatory disease
- protozoan
- replicate in specific host cells -> cell destruction
- metazoan parasites
- inflammation, tissue distortion, utilization of host nutrients
What are immune dysfunctions that cause cell injury?
immune system fails to respond to infectious agents
(test question)
- congenital defects: SCIDS (Arabian foals, lymphocytes not fully developed)
-
acquired defects
- may be transient (but not always)
- results from damage to lymphoid tissue (steroids)
- viral infections, chemicals, drugs
- autoimmune diseases
- hypersensitivity reactions (overzealous mast cells, eosinophils)
Manifestation of cell injury is variable depending on:
type of agent, extent of injury, duration of injury, cell type
6 mechanisms of cell injury:
- decreased ATP
- mitochondria damage
- entry of Ca++
- increased reactive oxygen species
- membrane damage
- protein misfolding/DNA damage
- all mechanisms have multiple effects on cells; cells have systems in place to mediate and repair damage; severe damage leads to cell apoptosis or necrosis

Explain the mechanism of cell injury: “depletion of ATP”
(test question)
- ATP is required for almost all synthetic and degradative processes within the cell
- associated with hypoxic injury and toxic injury (e.g. cyanide stops the electron transport chain)
- fundamental cause of necrotic cell death
-
depletion of 5-10% = BAD
-
NA+ K+ ATPase pump failure
- cell swelling, ER swelling, plasma membrane damage
- altered cell metabolism
- anaerobic glycolysis: increased lactic acid -> decreased pH -> loss of enzyme function
- ribosome detachment
- decreased protein synthesis
-
NA+ K+ ATPase pump failure
- culminates in irreversible mitochondrial and lysosomal membrane damage -> cell necrosis (cell swelling)

Explain the mechanism of cell injury: “mitochondrial damage”
(test question)
3 major consequences:
- formation of the mitochondrial permeability transition pore (MPTP, forms in outer membrane of mitochondria)
- production of reactive oxygen species
- activation of apoptotic pathways

Explain the mechanism of cell injury: “loss of calcium homeostasis”
(test question)
accumulation Ca++
- opening of MPTP -> decreased ATP
- enzyme activation (phospholipases, proteases, endonucleases, ATPases)
- activation of caspases -> induction of apoptosis

Explain the mechanism of cell injury: “accumulation of reactive oxygen-derived free-radicals”
(test question)
mechanism:
- unstable configuration
- interacts with adjacent molecules: proteins, lipids, carbohydrates, nucleic acids, etc.
- initiates autocatalytic reactions

Mechanism of cell injury: “inflammation”
- recognition and attachment: microbe bind to phagocyte receptors
- engulfment: phagocyte membrane zips up around microbe
- killing and degradation

What are pathologic effects of free radicals?
(test question)
- lipid peroxidation in membranes
- MOA: forms peroxides -> autocatalytic reaction (propagation)
- extensive membrane damage
- oxidative modification of proteins
- MOA: oxidation of amino acid side changes, formation of protein cross-linkages (disulfide bonds), oxidation of protein backbone
- damage active sites, change conformation, enhance degradation
- lesions in DNA
- MOA: single or double stranded breaks, cross-linking of DNA strands, formation of adducts
- cell aging, malignant transformation

What are the ways to remove free radicals
- spontaneous decay O2*(superoxide anion) + H2O -> O2 + H2O2
-
antioxidants (donors of electron): vitamin E, vitamin A, glutathione
- blocks initiation, inactivate (scavenge)
-
storage and transport proteins: transferrin, ferritin, ceruloplasmin
- bind reactive metals (Fe, Cu)
-
enzymes: catalase, superoxide dismutase, glutathione peroxidase
- break down H2O2 and O2*
- located near sites where oxidants are formed
- ex. superoxide dismutase (SOD) in mitochondria (endogenous) 2O2* + 2H + SOD -> H2O2 + O2
What are reactive oxygen species (ROS)?
(test question)
a type of oxygen-derived free radical; degraded and removed by cell defense systems;
production by:
- during mitochondrial respiration
- absorption of radiant energy
- inflammation
- enzymatic metabolism of drugs or toxins
- transition metals (Fe, Cu)